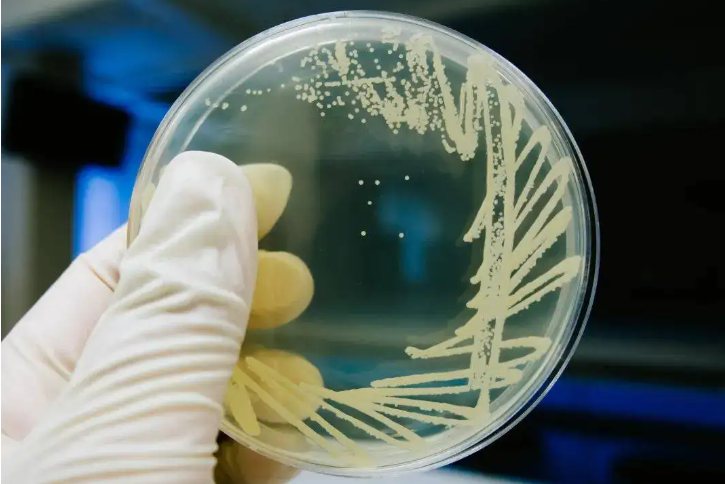
真菌培养

汗斑图片鉴别方法
创始人
2024-04-07 05:50:55
0次
概述
汗斑指花斑糠疹,又称花斑癣,是由马拉色菌累及皮肤角质层所致的慢性表浅真菌感染。
汗斑由马拉色菌感染导致,此外还受环境、个体素质等因素的影响,并且具有一定的遗传易感性。病变多发生在前胸、肩背、腋窝等皮脂腺分泌旺盛的部位。
鉴别
临床上的检验鉴别方法有以下几个方面:
1、皮损处鳞屑直接镜检
用钝刀刮取或胶带粘贴花斑糠疹患者皮损处的鳞屑,在显微镜下可以观察到弯曲或弧形短菌丝,和(或)成群厚壁圆形或芽生孢子,这是花斑糠疹的特征性表现。

2、真菌培养
刮取部分皮损的鳞屑,然后接种到含菜籽油或橄榄油的培养基上培养。若有奶油色酵母样菌落生成,则有助于诊断。
3、伍德灯检查
在光线较暗的房间里通过伍德灯照射患处皮损,皮损呈浅黄色或淡棕色荧光,则可确诊为花斑糠疹。

治疗
本病以局部外用抗真菌药物治疗为主,如果皮损面积大或单纯外用药疗效不佳,可口服抗真菌药物进行治疗。
上一篇:痱子和荨麻疹图片对照
相关内容
热门资讯
鼻毛为什么会变白 鼻毛为什么会...
鼻毛变白的原因可有多种,可能是衰老所致,也可能是疾病所致。鼻毛与眉毛、头发一样,颜色主要是由鼻部毛囊...
甘草泡地龙的功效与作用用量 甘...
甘草泡地龙的功效与作用包括清热解毒、祛痰止咳、调和气血,详情如下:1.清热解毒甘草和地龙都有清热解毒...
维a酸乳膏一个月效果图男士 维...
概述维A酸乳膏是一种能影响骨的生长和上皮代谢的外用药,常用于辅助治疗寻常痤疮、皮肤角化症等疾病。寻常...
腰椎打了4个钢钉多久能工作 腰...
腰椎打了4个钢钉多久能工作受到恢复情况以及腰椎受损严重程度的影响,一般在2-3个月后就能工作。腰椎打...
女人吃桂附地黄丸吃多久一疗程 ...
桂附地黄丸女人吃了可以达到温补肾阳的功效,能够改善肾阳不足所引起的临床症状。女性在出现肾阳不足之后就...
后脑勺有横着的肉杠是脑梗纹吗 ...
概述后脑勺有横着的肉杠可能是因过度肥胖病或脂肪瘤等因素引起。为预防后脑勺出现横着的肉杠,要适度减肥、...
槲皮素和铁皮石斛是一样的功效吗
槲皮素和铁皮石斛的功效不同,但它们有一些相似之处。槲皮素和铁皮石斛对人体的功效是不同的。槲皮素是一种...
丹参滴丸和麝香保心丸同吃行吗 ...
丹参滴丸即复方丹参滴丸,与麝香保心丸二者虽然都常用于冠状动脉粥样硬化性心脏病的预防、治疗和急救,但在...
正常结痂化脓结痂图片对比
概述结痂是伤口愈合过程中的一个阶段。正常结痂的伤口肉芽组织和结痂体紧密结合,结痂处轻微发红,无流脓情...
身上红色的小血点像痣倪海厦 身...
这类红色小血点,应该视情况而定。若是刚出生的小婴儿,则可能是毛细血管痣,也即是人们口中常常提到的“胎...